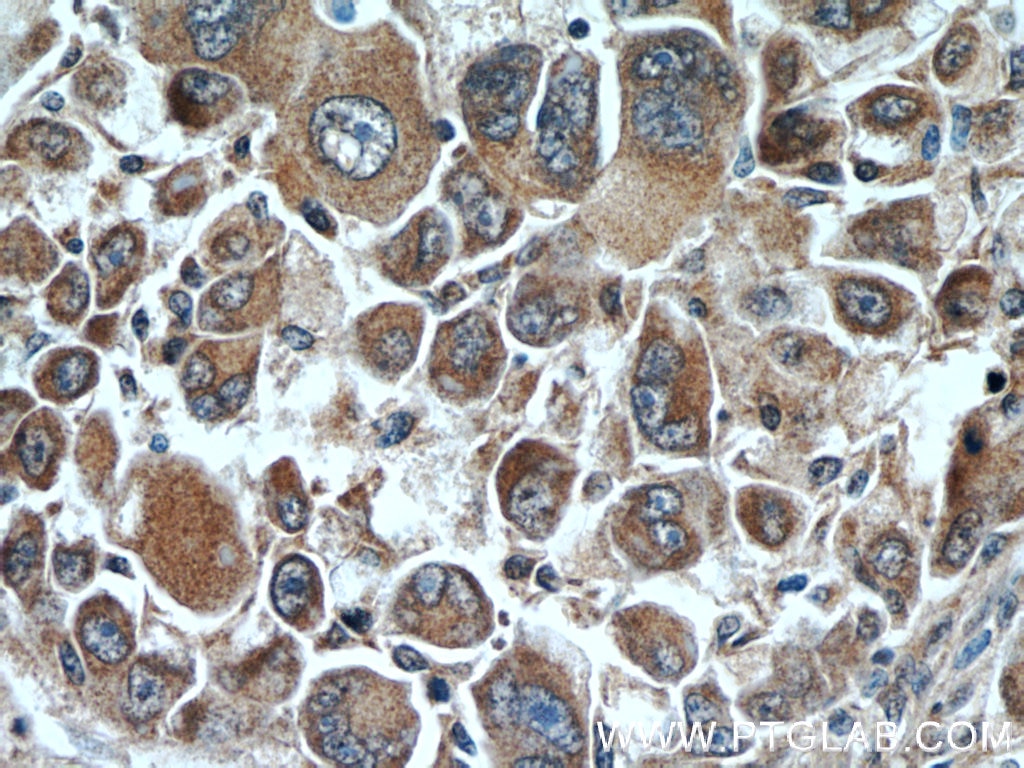

bartleby com

dopa zip episode 5 dimension of the

spectral signatures of l dopa induced

l dopa print shop wallpapers nik

avengers endgame logo wallpaper

dailymotion
dopa decarboxylase antibody 10166 1 ap

dopa decarboxylase antibody 10166 1 ap

dopa responsive dystonia

nik schulz illustration

quotefancy

kpopwallpaper hashtag on twitter

stimulation and l dopa administration

rose online wallpaper 15 rose online

coop dopa hostel in bangkok room

classic cars l dopa design illustration

reactive mesoporous silica

dopa certified home facebook

amazon in

pillsync com

160 dopa apdo highlight ideas twisted

high noon twisted fate wallpaper lol

l dopa design illustration

free download best pc backgrounds hd

https www shutterstock com image vector different scenes athletes using doping concept 1843155505

dopa apdo 도파 league of legends

wallpapersafari

ppt understanding l dopa transport

iconic automobile wallpapers car

l dopa print shop wallpapers nik
You May Like